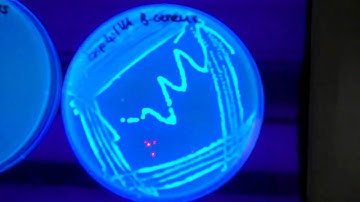
Fluorescent detection of nitroreductase activity

⬇ DOWNLOAD NOW
Kalau muncul iklan pop-up, tutup lalu klik tombol kembali
Download lagu Detection Of Bacteria Using Fluorogenic DNAzymes l Protocol Preview secara gratis hanya untuk keperluan promosi. Dukung artis favorit kamu dengan membeli musik original di iTunes atau platform resmi lainnya.
 F014 ZediXcite Fluorogenic TG2-Assay Kit
F014 ZediXcite Fluorogenic TG2-Assay Kit
 Chromogenic Agar Medium for the Detection of Vibrio Species | Protocol Preview
Chromogenic Agar Medium for the Detection of Vibrio Species | Protocol Preview
 DNAzyme-dependent Analysis of rRNA O-Methylation | Protocol Preview
DNAzyme-dependent Analysis of rRNA O-Methylation | Protocol Preview
 The Evolution of Bacteria on a “Mega-Plate” Petri Dish (Kishony Lab)
The Evolution of Bacteria on a “Mega-Plate” Petri Dish (Kishony Lab)
 Bacteriophage T4: Recombination Assay
Bacteriophage T4: Recombination Assay
 Understanding bacteria’s role in transforming steroids to pharmaceuticals
Understanding bacteria’s role in transforming steroids to pharmaceuticals
Fluorescent detection of nitroreductase activity
Fluorescent detection of nitroreductase activity
 Berkeley Lab in the Fight: Fluorescent Sensors to Detect SARS-CoV-2 Contamination on PPE
Berkeley Lab in the Fight: Fluorescent Sensors to Detect SARS-CoV-2 Contamination on PPE